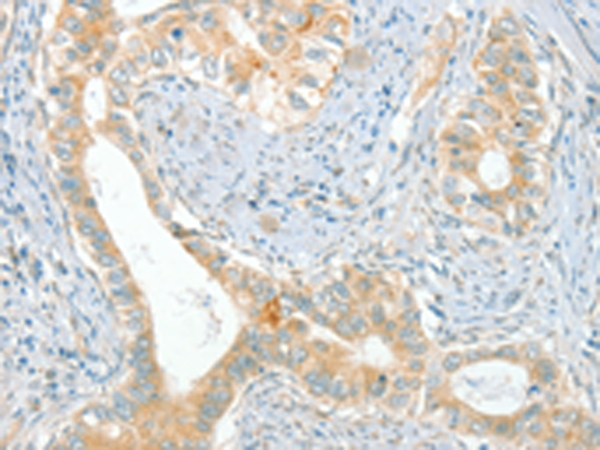

中文名稱:兔抗ACE多克隆抗體
英文名稱: Anti-ACE rabbit polyclonal antibody
別 名: DCP; ICH; ACE1; DCP1; CD143; MVCD3
相關(guān)類別: 一抗
儲 存: 冷凍(-20℃)
抗 原: ACE
宿 主: Rabbit
反應(yīng)種屬: Human, Mouse, Rat
標(biāo) 記 物: Unconjugate
克隆類型: rabbit polyclonal
技術(shù)規(guī)格
|
Background: |
This gene encodes an enzyme involved in catalyzing the conversion of angiotensin I into a physiologically active peptide angiotensin II. Angiotensin II is a potent vasopressor and aldosterone-stimulating peptide that controls blood pressure and fluid-electrolyte balance. This enzyme plays a key role in the renin-angiotensin system. Many studies have associated the presence or absence of a 287 bp Alu repeat element in this gene with the levels of circulating enzyme or cardiovascular pathophysiologies. Multiple alternatively spliced transcript variants encoding different isoforms have been identified, and two most abundant spliced variants encode the somatic form and the testicular form, respectively, that are equally active. |
|
Applications: |
ELISA, WB, IHC |
|
Name of antibody: |
ACE |
|
Immunogen: |
Synthetic peptide of human ACE |
|
Full name: |
angiotensin I converting enzyme |
|
Synonyms: |
DCP; ICH; ACE1; DCP1; CD143; MVCD3 |
|
SwissProt: |
P12821 |
|
ELISA Recommended dilution: |
1000-2000 |
|
IHC positive control: |
Human cervical cancer and Human breast cancer |
|
IHC Recommend dilution: |
50-200 |
|
WB Predicted band size: |
150 kDa |
|
WB Positive control: |
Human ileum adenocarcinoma tissue, Human testis and prostate tissue |
|
WB Recommended dilution: |
200-1000 |

購物車
幫助
021-54845833/15800441009
